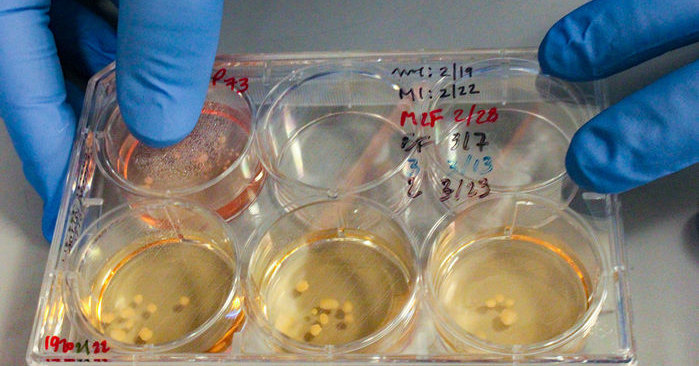
Ученые вырастили клетки мозга неандертальца

В мае группа ученых под руководством антрополога Сванте Паабо начала эксперимент по выращиванию органоидов коры головного с мутацией, обнаруженной в ДНК неандертальцев. Такую же работу ведут исследователи из некоторых других институтов, и на прошлой неделе группа под руководством Элиссона Мюотри (Alysson Muotri) из Калифорнийского университета из Сан-Диего рассказала о первых результатах; пока их статья готовится к публикации, ученые сделали доклад на конференции Imagination and Human Evolution.
Американские ученые работали с одной мутацией, характерной для неандертальского генома — мутацией в гене NOVA1, который экспрессируется в нейронах и «молчит» во всех остальных клетках организма. Ее внесли в ДНК человеческих клеток-фибробластов с помощью технологии редактирования генома CRISPR/Cas9. Потом фибробласты вернули к состоянию плюрипотентных стволовых клеток и направили их по пути развития нейрона — клетки коры головного
Белок, который кодируется геном NOVA1, регулирует сплайсинг РНК; другими словами, от него зависит, какие белки получатся в результате экспрессии других генов. У человека современного типа мутации в NOVA1 связаны с некоторыми видами рака. Неандертальский вариант этого гена рака не вызвал, но совершенно изменил форму и характер связей между нейронами органоида. Нейронные агрегаты из контрольной группы, без неандертальского варианта, имели сферическую форму, геометрия «неандертальских» органоидов оказалась более сложной. Кроме того, мутация изменила скорость миграции зрелых нейронов и количество синаптических связей, образованных между клетками — их оказалось меньше.
Работа Мюотри стала только первым шагом к пониманию того, как был устроен и как работал






